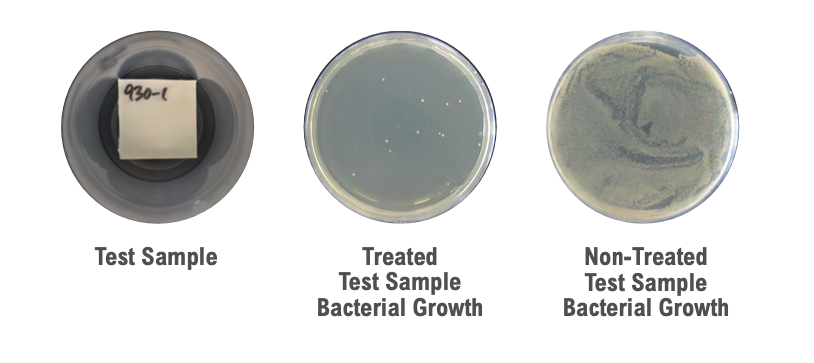

New KYDEX® ION Technology™ is 99% effective at inhibiting the growth of stain and odor causing bacteria on KYDEX® Thermoplastics. KYDEX® ION Technology™ interferes with bacteria DNA, which prevents stain and odor causing bacteria from multiplying on the treated thermoplastic sheet.
KYDEX® ION Technology™ is an antimicrobial treatment incorporated into the sheet, which helps keep the treated surface cleaner between cleanings. Durable, chemical- and stain-resistant, KYDEX® Thermoplastics are ideal for high touch areas such as checkout stands, counter tops, point of sale, healthcare furniture, medical devices, kiosks, tray tables, and wall coverings.





| KYDEX ION Technology™ | Click button to view Tech Data Sheet | ISO 22196* |
JIS Z 2801* |
FAR 25.853 (a) (d) |
ASTM E84 |
UL94 | Chemical Resistance to Disinfectants |
|---|---|---|---|---|---|---|---|
| KYDEX® 5555HI-ION Aviation – high impact, extreme low heat release & smoke | Tech Data Sheet | ||||||
| KYDEX® 6565HI-ION Aviation – high impact, low heat release & smoke | Tech Data Sheet | ||||||
| KYDEX® XD-ION Flat lamination & membrane pressing | Tech Data Sheet | ||||||
| KYDEX® XD03 ION Pearlescent for flat lamination & membrane pressing | Tech Data Sheet | ||||||
| KYDEX® T-ION High impact fire-rated | Tech Data Sheet |
KYDEX ION Technology™
Tap below to view Tech Data Sheets & certifications
KYDEX® 5555HI-ION
Aviation – high impact, extreme low heat release & smoke
KYDEX® 6565HI-ION
Aviation – high impact, low heat release & smoke
KYDEX® XD-ION
Flat lamination & membrane pressing
KYDEX® XD03 ION
Pearlescent for flat lamination & membrane pressing

*Disclaimer: *KYDEX® Thermoplastics incorporate an advanced EPA-registered antimicrobial for the protection and preservation of our polymeric and plastic materials. KYDEX® Thermoplastics are treated only to protect the polymeric and plastic materials and do not confer protection from bacteria to users of our products. Always clean the product thoroughly after use. To learn more about KYDEX ION Technology™ or to have a technical conversation, contact our appLab™ team at appLab@kydex.com or 800.682.8758.
KYDEX® ION Technology™ is an antimicrobial treatment incorporated into the sheet, which helps keep the treated surface cleaner between cleanings.
AVIATION
KYDEX® 5555HI-ION
- Designed to provide extremely low heat & smoke release
- High performance thermoplastic sheet with integral colour
- Engineered to improve aircraft passenger safety
- Improved impact characteristics for components subjected to HIC (Head Impact Criterion) testing
KYDEX® 6565HI-ION
- High performance thermoplastic sheet with integral colour
- Engineered to improve aircraft passenger safety
- Improved impact characteristics for components subjected to HIC (Head Impact Criterion) testing
SURFACES
KYDEX® XD-ION
- 3D laminate used to create
seamless edges, eliminating
edge banding - Superior impact resistance
- Integral color
- Improved impact characteristics for components subjected to HIC (Head Impact Criterion) testing
KYDEX® XD03 ION
- Designed to provide extremely low heat & smoke release
- High performance thermoplastic sheet with integral colour
- Engineered to improve aircraft passenger safety
- Improved impact characteristics for components subjected to HIC (Head Impact Criterion) testing
KYDEX® T-ION
- Designed to provide extremely low heat & smoke release
- High performance thermoplastic sheet with integral colour
- Engineered to improve aircraft passenger safety
- Improved impact characteristics for components subjected to HIC (Head Impact Criterion) testing
Cleanability & Chemical Resistance
Aggressive disinfectants are critical in eliminating surface bacteria and fungi to reduce the spread of disease.
Testing results confirmed that most KYDEX® Thermoplastics:
- are not adversely affected by industry leading cleaners and disinfectants
- perform without loss of surface finish, colour fastness, or degradation of mechanical and physical properties
Using the right materials and understanding their compatibility with disinfectants is vital to ensuring a long, functional life.
KYDEX® Thermoplastics with Infused Imaging™ technology provides the look of texture on a flat surface that can be easily cleaned and disinfected.
- proprietary process that embeds imagery into thermoplastic material
- can be used with KYDEX® ION TechnologyTM and KYDEX® MB (antimicrobial) thermoplastics

